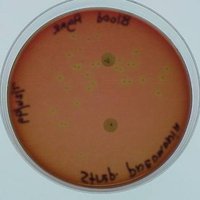
Alpha hemolysis on blood agar
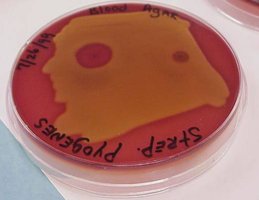
Beta hemolysis on blood agar

Back
BackMicrobial Diseases of the Skin and Eyes: Structure, Normal Flora, and Pathogenesis
Study Guide - Smart Notes

Diseases of the Skin and Eyes
Introduction
The skin and eyes serve as critical barriers against microbial invasion. This chapter explores the structure and defenses of the skin, the normal microbiota, and the major bacterial, viral, fungal, and parasitic diseases affecting these organs. Understanding these topics is essential for recognizing, diagnosing, and managing infectious diseases in clinical practice.
Structure and Defenses of the Skin
Physical and Chemical Barriers
Skin is the body's first line of defense, providing a physical and ecological barrier to pathogens.
Key defensive features include:
Acidic secretions (low pH)
Dryness (except in moist areas like the axilla)
Exposure to radiation (UV light)

Figure: The structure of human skin, showing layers and associated structures such as hair follicles, sweat glands, and sebaceous glands.
Perspiration and sebum provide nutrients for some microbes but also contain antimicrobial substances:
Salt inhibits microbial growth
Lysozyme hydrolyzes peptidoglycan in bacterial cell walls
Fatty acids inhibit certain pathogens
Antimicrobial peptides (defensins) disrupt microbial membranes
Mucous Membranes
Line body cavities and are composed of tightly packed epithelial cells attached to an extracellular matrix.
Cells secrete mucus and may have cilia to trap and remove microbes.
Often acidic and washed by fluids containing lysozyme (e.g., tears in the eyes).
Normal Microbiota of the Skin
Characteristics and Composition
Normal microbiota are resistant to drying and high salt concentrations.
Major groups include:
Staphylococci (secrete antimicrobials)
Micrococci (secrete antimicrobials)
Diphtheroids
Corynebacterium xerosis (aerobic, surface-dwelling)
Propionibacterium acnes (anaerobic, hair follicles, produces acids to maintain low pH)
Malassezia furfur (yeast, responsible for dandruff)
Areas with moisture (e.g., armpits) have higher microbial populations.
Microbiota metabolize sweat and oils, contributing to body odor and maintaining skin pH.
Microbial Diseases of the Skin
Definitions
Exanthem: Skin rash arising from another focus of infection.
Enanthem: Mucous membrane rash arising from another focus of infection (e.g., in the mouth).
Types of Skin Lesions
Vesicle: Small, fluid-filled lesion (<1 cm)
Bulla: Larger fluid-filled lesion (>1 cm)
Macule: Flat, reddened lesion
Pustule (Papule): Raised lesion containing pus
Bacterial Diseases of the Skin
Staphylococcal Skin Infections
Staphylococcus epidermidis: Gram-positive cocci, coagulase-negative, common on skin, forms biofilms on catheters.
Staphylococcus aureus: Gram-positive cocci, coagulase-positive, carried in nasal passages, produces toxins, can cause sepsis, and is often antibiotic-resistant (MRSA).

Figure: Staphylococcal biofilm formation on a catheter, a key factor in healthcare-associated infections.
Virulence factors of S. aureus:
Yellow pigment
Coagulase (clots fibrin, protects from phagocytes)
Toxins: Enterotoxins (diarrhea), Leukocidins (destroy leukocytes), Exfoliative toxin (scalded skin syndrome), Superantigen (toxic shock syndrome)
Resists opsonization and lysozyme
Survives in phagolysosome
Common Staphylococcal Skin Infections
Folliculitis: Infection of hair follicles
Sty: Folliculitis of an eyelash
Furuncle: Abscess; pus surrounded by inflamed tissue
Carbuncle: Inflammation of tissue under the skin
Impetigo: Crusting sores, spread by autoinoculation


Figure: Lesions of impetigo, a common superficial skin infection.
Scalded Skin Syndrome: Caused by exfoliative toxin from lysogenized S. aureus; characterized by peeling skin, often in children under 2 years.


Figure: Scalded skin syndrome, showing extensive peeling and redness.
Streptococcal Skin Infections
Streptococcus pyogenes: Group A beta-hemolytic Streptococci, grows in chains, produces hemolysins, hyaluronidase, streptokinases, M proteins, and exotoxins.

Figure: M protein on the surface of Streptococcus pyogenes, a major virulence factor.
Hemolytic reactions:
Alpha hemolysis: Green zone (partial hemolysis)
Beta hemolysis: Clear zone (complete hemolysis)
Gamma hemolysis: No hemolysis

Figure: Hemolytic patterns of Streptococcus species on blood agar.
Impetigo: Superficial infection, pustules become crusted and rupture, common in children.



Erysipelas: Infection of the dermis, reddish patches with raised margins, can lead to sepsis.


Necrotizing Fasciitis: Rapidly spreading infection destroying tissue, high mortality, often caused by S. pyogenes producing exotoxin A (superantigen).


Infections by Pseudomonads
Pseudomonas aeruginosa: Gram-negative, aerobic rod, produces blue-green pus (pyocyanin), grows in biofilms, opportunistic in burn victims, resistant to many antibiotics.
Common infections: Folliculitis (hot tub rash), otitis externa (swimmer's ear), biofilm-associated infections in medical devices and cystic fibrosis lungs.


Buruli Ulcer
Caused by Mycobacterium ulcerans, enters via skin breaks or insect bites, causes deep ulcers, prevalent in Africa, treated with antibiotics and surgery.
Acne
Most common skin disease, caused by blockage of hair follicles by sebum and shed cells.
Comedonal (mild) acne: Blocked sebum channels, treated with topical agents.
Inflammatory (moderate) acne: Due to Propionibacterium acnes, treated with antibiotics, benzoyl peroxide, or blue light.
Nodular cystic (severe) acne: Deep inflamed lesions, treated with isotretinoin.

Viral Diseases of the Skin
Warts
Caused by papillomaviruses, transmitted by contact, variable appearance, treated by removal (cryotherapy, salicylic acid, etc.).



Poxviruses
Smallpox (variola): Eradicated by vaccination, transmitted via respiratory route, high mortality for variola major, potential bioterrorism agent.
Monkeypox: Zoonotic, prevented by smallpox vaccine.
Chickenpox and Shingles
Caused by Varicella-zoster virus (HHV-3), transmitted by respiratory route, causes vesicular rash, can remain latent and reactivate as shingles.
Prevention: Live attenuated vaccine.
Herpes Simplex
Caused by HSV-1 (oral, latent in trigeminal ganglia) and HSV-2 (genital, latent in sacral ganglia).
Causes cold sores, herpetic whitlow, and rarely encephalitis.
Measles (Rubeola)
Caused by measles virus, transmitted by respiratory route, causes macular rash and Koplik's spots, prevented by MMR vaccine.
Rubella (German Measles)
Caused by rubella virus, mild rash, can cause severe congenital defects if contracted during pregnancy, prevented by vaccination.
Other Viral Exanthems
Fifth Disease (erythema infectiosum): Caused by parvovirus B19, "slap-cheek" rash.
Roseola: Caused by HHV-6/7, high fever followed by rash.
Hand-foot-and-mouth disease: Caused by enteroviruses, common in children.
Fungal Diseases of the Skin and Nails
Cutaneous Mycoses (Dermatomycoses)
Caused by dermatophytes (e.g., Trichophyton, Epidermophyton, Microsporum), infect hair, skin, and nails, metabolize keratin.
Common types: Tinea capitis (scalp), tinea cruris (jock itch), tinea pedis (athlete's foot).
Treatment: Topical or oral antifungals.
Subcutaneous Mycoses
More serious, often from puncture wounds (e.g., sporotrichosis caused by Sporothrix schenkii).
Candidiasis
Caused by Candida albicans, affects skin and mucous membranes, common after antibiotic use, can cause thrush.
Treatment: Topical or systemic antifungals.
Parasitic Infestations of the Skin
Scabies
Caused by Sarcoptes scabiei (mites), intense itching, transmitted by close contact, treated with topical insecticides.
Pediculosis (Lice)
Caused by Pediculus humanus capitis (head louse) and P. h. corporis (body louse), feed on blood, lay eggs (nits) on hair, treated with topical insecticides.
Microbial Diseases of the Eye
Bacterial Diseases
Conjunctivitis (pinkeye): Inflammation of conjunctiva, commonly caused by Haemophilus influenzae or Pseudomonads (especially with unsanitary contact lenses).
Ophthalmia neonatorum: Caused by Neisseria gonorrhoeae, transmitted during birth, can cause blindness if untreated, prevented by antibiotic eye drops at birth.
Chlamydia trachomatis: Causes inclusion conjunctivitis and trachoma (leading cause of blindness worldwide), transmitted by contact or flies, treated with antibiotics.
Other Infectious Diseases of the Eye
Keratitis: Inflammation of the cornea, caused by bacteria or fungi (e.g., Fusarium, Aspergillus).
Herpetic keratitis: Caused by HSV-1, can lead to blindness, treated with antivirals.
Acanthamoeba keratitis: Protozoan infection, associated with unsanitary contact lenses, may require corneal transplant.
